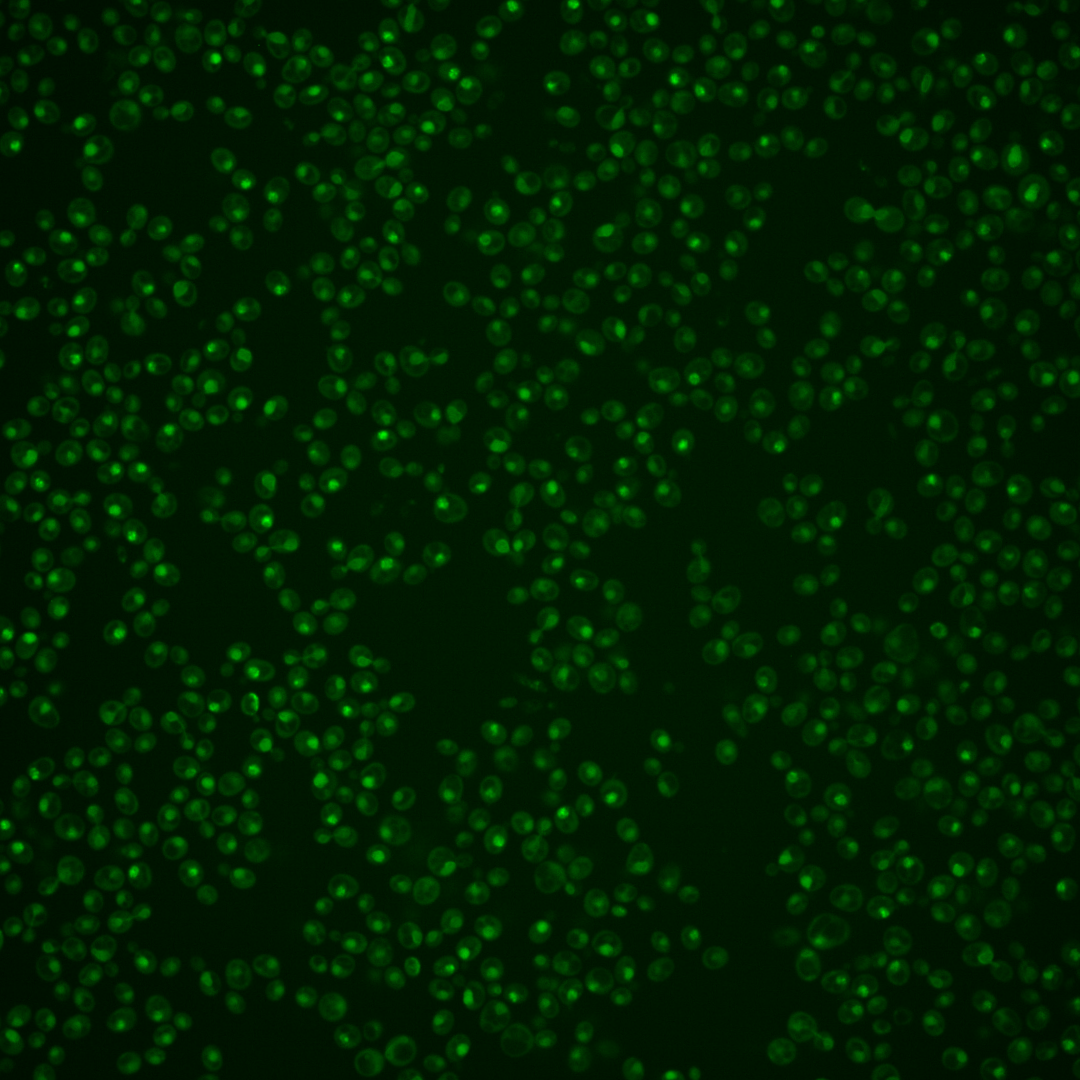

| Standard name | |
|---|---|
| Human Ortholog | |
| Description | B subunit of DNA polymerase alpha-primase complex; required for initiation of DNA replication during mitotic and premeiotic DNA synthesis; also functions in telomere capping and length regulation |
Micrographs




















































































Sub-cellular Localization
Yeast GFP Assignment
Protein Abundance
Localization Change
External localization resources
| ensLOC | DeepLoc | |||||||||||||||||||||||
|---|---|---|---|---|---|---|---|---|---|---|---|---|---|---|---|---|---|---|---|---|---|---|---|---|
| Localization | WT1 | WT2 | WT3 | RAP60 | RAP140 | RAP220 | RAP300 | RAP380 | RAP460 | RAP540 | RAP620 | RAP700 | HU80 | HU120 | HU160 | rpd3Δ_1 | rpd3Δ_2 | rpd3Δ_3 | WT1 | WT2 | WT3 | AF100 | AF140 | AF180 |
| Cortical Patches | 0 | 0 | 1 | 0 | 0 | 0 | 0 | 0 | 0 | – | 0 | 0 | 0 | 0 | 0 | 0 | 0 | 0 | 1 | 1 | 1 | 0 | 0 | 0 |
| Bud | 0 | 0 | 0 | 0 | 2 | 0 | 2 | 8 | 5 | – | 8 | 6 | 0 | 0 | 0 | 0 | 0 | 0 | 4 | 3 | 0 | 0 | 0 | 2 |
| Bud Neck | 0 | 0 | 0 | 0 | 0 | 0 | 1 | 0 | 1 | – | 0 | 0 | 0 | 0 | 0 | 0 | 0 | 0 | 0 | 0 | 0 | 0 | 0 | 1 |
| Bud Site | 0 | 0 | 0 | 1 | 3 | 8 | 6 | 5 | 13 | – | 5 | 12 | 0 | 0 | 1 | 0 | 0 | 0 | – | – | – | – | – | – |
| Cell Periphery | 0 | 0 | 0 | 0 | 0 | 0 | 0 | 0 | 0 | – | 0 | 0 | 0 | 0 | 0 | 2 | 2 | 0 | 0 | 0 | 0 | 0 | 0 | 0 |
| Cytoplasm | 9 | 7 | 8 | 10 | 16 | 11 | 20 | 18 | 8 | – | 8 | 15 | 3 | 18 | 28 | 49 | 9 | 23 | 0 | 0 | 0 | 0 | 0 | 0 |
| Endoplasmic Reticulum | 0 | 1 | 1 | 0 | 0 | 0 | 3 | 0 | 0 | – | 0 | 0 | 0 | 0 | 0 | 13 | 7 | 9 | 0 | 0 | 0 | 0 | 1 | 2 |
| Endosome | 1 | 1 | 2 | 0 | 0 | 1 | 0 | 0 | 0 | – | 0 | 0 | 0 | 0 | 0 | 3 | 1 | 2 | 2 | 0 | 3 | 0 | 0 | 3 |
| Golgi | 0 | 0 | 2 | 0 | 0 | 0 | 0 | 0 | 0 | – | 0 | 0 | 0 | 0 | 0 | 2 | 1 | 5 | 1 | 0 | 3 | 0 | 0 | 1 |
| Mitochondria | 9 | 12 | 3 | 15 | 9 | 67 | 89 | 52 | 195 | – | 244 | 134 | 5 | 1 | 4 | 6 | 2 | 5 | 2 | 2 | 7 | 0 | 1 | 3 |
| Nucleus | 223 | 304 | 410 | 297 | 423 | 438 | 625 | 528 | 481 | – | 434 | 617 | 112 | 145 | 188 | 287 | 199 | 240 | 208 | 295 | 379 | 28 | 107 | 98 |
| Nuclear Periphery | 17 | 19 | 9 | 13 | 35 | 25 | 44 | 24 | 24 | – | 17 | 22 | 5 | 1 | 3 | 29 | 17 | 25 | 18 | 8 | 18 | 1 | 0 | 1 |
| Nucleolus | 21 | 22 | 5 | 8 | 6 | 22 | 26 | 19 | 33 | – | 57 | 53 | 8 | 11 | 17 | 13 | 7 | 3 | 13 | 10 | 12 | 0 | 2 | 6 |
| Peroxisomes | 0 | 0 | 0 | 0 | 0 | 0 | 0 | 0 | 0 | – | 0 | 0 | 0 | 0 | 0 | 1 | 0 | 0 | 0 | 0 | 0 | 0 | 0 | 0 |
| SpindlePole | 1 | 0 | 3 | 1 | 4 | 5 | 3 | 9 | 2 | – | 1 | 6 | 0 | 0 | 3 | 3 | 1 | 1 | 2 | 1 | 1 | 0 | 0 | 2 |
| Vac/Vac Membrane | 17 | 21 | 25 | 7 | 31 | 19 | 38 | 20 | 16 | – | 18 | 22 | 1 | 2 | 2 | 105 | 58 | 68 | 12 | 19 | 21 | 2 | 28 | 30 |
| Unique Cell Count | 259 | 335 | 441 | 318 | 471 | 501 | 738 | 610 | 572 | 583 | 738 | 120 | 168 | 227 | 458 | 273 | 341 | 268 | 346 | 453 | 38 | 148 | 160 | |
| Labelled Cell Count | 298 | 387 | 469 | 352 | 529 | 596 | 857 | 683 | 778 | 792 | 887 | 134 | 178 | 246 | 513 | 304 | 381 | 268 | 346 | 453 | 38 | 148 | 160 | |
Yeast GFP Assignment
Protein Abundance
| Screen | WT1 | WT2 | WT3 | RAP60 | RAP140 | RAP220 | RAP300 | RAP380 | RAP460 | RAP540 | RAP620 | RAP700 | HU80 | HU120 | HU160 | rpd3Δ_1 | rpd3Δ_2 | rpd3Δ_3 | AF100 | AF140 | AF180 |
|---|---|---|---|---|---|---|---|---|---|---|---|---|---|---|---|---|---|---|---|---|---|
| Mean Cell GFP Intensity (1e-4) | 6.2 | 7.1 | 6.6 | 5.9 | 6.5 | 5.2 | 5.6 | 5.9 | 4.7 | – | 4.5 | 5.2 | 6.6 | 7.8 | 6.6 | 9.6 | 9.5 | 9.2 | – | 5.8 | 6.1 |
| Std Deviation (1e-4) | 1.1 | 1.7 | 1.0 | 1.1 | 1.1 | 1.0 | 1.2 | 1.1 | 1.0 | – | 1.0 | 0.9 | 1.5 | 8.7 | 1.9 | 2.2 | 2.0 | 2.2 | – | 1.3 | 1.4 |
| Intensity Change (Log2) | – | – | – | -0.16 | -0.02 | -0.34 | -0.25 | -0.16 | -0.5 | – | -0.55 | -0.34 | 0.01 | 0.25 | -0.01 | 0.54 | 0.53 | 0.49 | – | -0.19 | -0.12 |
Localization Change
| Localization | RAP60 | RAP140 | RAP220 | RAP300 | RAP380 | RAP460 | RAP540 | RAP620 | RAP700 | HU80 | HU120 | HU160 | rpd3Δ_1 | rpd3Δ_2 | rpd3Δ_3 |
|---|---|---|---|---|---|---|---|---|---|---|---|---|---|---|---|
| Cortical Patches | 0 | 0 | 0 | 0 | 0 | 0 | – | 0 | 0 | 0 | 0 | 0 | 0 | 0 | 0 |
| Bud | 0 | 0 | 0 | 0 | 0 | 0 | – | 0 | 0 | 0 | 0 | 0 | 0 | 0 | 0 |
| Bud Neck | 0 | 0 | 0 | 0 | 0 | 0 | – | 0 | 0 | 0 | 0 | 0 | 0 | 0 | 0 |
| Bud Site | 0 | 0 | 0 | 0 | 0 | 0 | – | 0 | 0 | 0 | 0 | 0 | 0 | 0 | 0 |
| Cell Periphery | 0 | 0 | 0 | 0 | 0 | 0 | – | 0 | 0 | 0 | 0 | 0 | 0 | 0 | 0 |
| Cytoplasm | 1.2 | 1.5 | 0.4 | 1.0 | 1.2 | -0.5 | – | -0.6 | 0.3 | 0 | 4.9 | 5.7 | 5.5 | 1.3 | 3.5 |
| Endoplasmic Reticulum | 0 | 0 | 0 | 0 | 0 | 0 | – | 0 | 0 | 0 | 0 | 0 | 3.2 | 0 | 0 |
| Endosome | 0 | 0 | 0 | 0 | 0 | 0 | – | 0 | 0 | 0 | 0 | 0 | 0 | 0 | 0 |
| Golgi | 0 | 0 | 0 | 0 | 0 | 0 | – | 0 | 0 | 0 | 0 | 0 | 0 | 0 | 0 |
| Mitochondria | 3.6 | 1.6 | 7.4 | 7.0 | 5.6 | 0 | – | 0 | 9.1 | 0 | 0 | 0 | 0 | 0 | 0 |
| Nucleus | 0.2 | -1.7 | -2.8 | -4.2 | -3.3 | -4.3 | – | -7.7 | -4.6 | 0.1 | -2.6 | -4.1 | -10.9 | -7.4 | -8.4 |
| Nuclear Periphery | 1.7 | 3.8 | 2.4 | 3.1 | 1.7 | 0 | – | 0 | 1.0 | 0 | 0 | 0 | 3.2 | 2.9 | 3.6 |
| Nucleolus | 1.4 | 0.2 | 3.0 | 2.5 | 2.1 | 0 | – | 0 | 4.6 | 0 | 0 | 4.4 | 1.8 | 0 | 0 |
| Peroxisomes | 0 | 0 | 0 | 0 | 0 | 0 | – | 0 | 0 | 0 | 0 | 0 | 0 | 0 | 0 |
| SpindlePole | 0 | 0 | 0 | 0 | 1.2 | 0 | – | 0 | 0 | 0 | 0 | 0 | 0 | 0 | 0 |
| Vacuole | -2.3 | 0.6 | -1.4 | -0.4 | -1.9 | -2.3 | – | -2.0 | -2.3 | -2.2 | -2.4 | -3.0 | 7.4 | 6.3 | 6.1 |
External localization resources
Images






























Protein Concentration and Protein Localization Data
| R1 | R2 | R3 | ||||||||||||||||
|---|---|---|---|---|---|---|---|---|---|---|---|---|---|---|---|---|---|---|
| G1 Pre-START | G1 Post-START | S/G2 | Metaphase | Anaphase | Telophase | G1 Pre-START | G1 Post-START | S/G2 | Metaphase | Anaphase | Telophase | G1 Pre-START | G1 Post-START | S/G2 | Metaphase | Anaphase | Telophase | |
| Concentration | 1.6966 | 3.363 | 2.6133 | 2.18 | 1.6012 | 2.0298 | 3.2808 | 4.9721 | 4.5269 | 3.9756 | 3.5257 | 3.4903 | 3.395 | 4.7917 | 4.0949 | 3.6903 | 3.0112 | 3.7774 |
| Actin | 0.0047 | 0.0011 | 0.008 | 0.0005 | 0.0186 | 0.0001 | 0.0055 | 0 | 0.0049 | 0.0008 | 0.001 | 0.0002 | 0.0084 | 0 | 0.0124 | 0.0849 | 0.0011 | 0.0055 |
| Bud | 0.0001 | 0 | 0 | 0 | 0.0001 | 0 | 0.0003 | 0 | 0.0005 | 0.0001 | 0.0003 | 0 | 0.0002 | 0 | 0.0004 | 0.002 | 0.0004 | 0 |
| Bud Neck | 0.0003 | 0.0001 | 0.0001 | 0.0001 | 0.0005 | 0.0005 | 0.0011 | 0.0001 | 0.0005 | 0.0004 | 0.0016 | 0.0008 | 0.0007 | 0 | 0.0007 | 0.0016 | 0.0008 | 0.0004 |
| Bud Periphery | 0.0002 | 0.0001 | 0.0001 | 0.0001 | 0.0003 | 0.0001 | 0.0009 | 0 | 0.0008 | 0.0002 | 0.0008 | 0.0002 | 0.0005 | 0 | 0.0012 | 0.0032 | 0.0016 | 0.0001 |
| Bud Site | 0.0002 | 0.0002 | 0 | 0 | 0.0003 | 0 | 0.0009 | 0 | 0.0063 | 0.0002 | 0.0012 | 0.0001 | 0.0005 | 0 | 0.0009 | 0.0197 | 0.0003 | 0 |
| Cell Periphery | 0.0001 | 0 | 0 | 0 | 0.0001 | 0 | 0.0004 | 0 | 0.0002 | 0.0001 | 0.0005 | 0.0001 | 0.0001 | 0 | 0.0002 | 0.0009 | 0.0007 | 0 |
| Cytoplasm | 0.0034 | 0.0002 | 0.0001 | 0.0014 | 0.0013 | 0.0002 | 0.0019 | 0 | 0.0013 | 0.0015 | 0.0075 | 0.0002 | 0.0025 | 0.0001 | 0.0003 | 0.0159 | 0.0015 | 0.0001 |
| Cytoplasmic Foci | 0.005 | 0.0019 | 0 | 0 | 0.0038 | 0 | 0.0057 | 0 | 0.0069 | 0.0026 | 0.0017 | 0.0004 | 0.0108 | 0 | 0.003 | 0.026 | 0.0081 | 0.0004 |
| Eisosomes | 0.0002 | 0 | 0.0001 | 0 | 0.0002 | 0 | 0.0001 | 0 | 0 | 0 | 0.0001 | 0 | 0 | 0 | 0.0001 | 0.0008 | 0 | 0 |
| Endoplasmic Reticulum | 0.0018 | 0.0001 | 0.0004 | 0.001 | 0.003 | 0.0004 | 0.0027 | 0 | 0.0005 | 0.0003 | 0.0066 | 0.0009 | 0.0016 | 0.0002 | 0.0005 | 0.0072 | 0.0013 | 0.0003 |
| Endosome | 0.006 | 0.0003 | 0.0003 | 0.0005 | 0.0141 | 0.0001 | 0.0082 | 0 | 0.009 | 0.0027 | 0.0267 | 0.004 | 0.0147 | 0 | 0.006 | 0.0571 | 0.0019 | 0.0002 |
| Golgi | 0.0036 | 0.0007 | 0.0004 | 0 | 0.0032 | 0 | 0.0061 | 0 | 0.0047 | 0.0038 | 0.0038 | 0.0007 | 0.0026 | 0 | 0.0045 | 0.0198 | 0.0004 | 0.0002 |
| Lipid Particles | 0.0105 | 0.0024 | 0 | 0.0002 | 0.007 | 0 | 0.01 | 0 | 0.0078 | 0.0231 | 0.0046 | 0.001 | 0.0124 | 0 | 0.0061 | 0.0602 | 0.0014 | 0.0003 |
| Mitochondria | 0.0125 | 0.0007 | 0.0004 | 0.0009 | 0.0019 | 0.0004 | 0.0208 | 0.0001 | 0.0086 | 0.0032 | 0.0076 | 0.0011 | 0.0021 | 0.0003 | 0.0054 | 0.0309 | 0.0118 | 0.0011 |
| None | 0.0163 | 0.0001 | 0 | 0.0032 | 0.0052 | 0 | 0.0031 | 0 | 0.0005 | 0.001 | 0.0006 | 0.0002 | 0.0022 | 0 | 0.0002 | 0.0054 | 0.0012 | 0.0001 |
| Nuclear Periphery | 0.0688 | 0.0473 | 0.0619 | 0.3508 | 0.4746 | 0.0904 | 0.037 | 0.0155 | 0.0651 | 0.3731 | 0.4743 | 0.0684 | 0.0292 | 0.0787 | 0.0292 | 0.206 | 0.233 | 0.0856 |
| Nucleolus | 0.0173 | 0.0264 | 0.0162 | 0.0024 | 0.0038 | 0.0368 | 0.02 | 0.0162 | 0.0202 | 0.0032 | 0.0256 | 0.0289 | 0.0105 | 0.0072 | 0.0109 | 0.0192 | 0.0457 | 0.0146 |
| Nucleus | 0.8228 | 0.9032 | 0.9096 | 0.6305 | 0.4393 | 0.8681 | 0.8517 | 0.9672 | 0.8486 | 0.5719 | 0.4102 | 0.8864 | 0.8709 | 0.9115 | 0.9116 | 0.3943 | 0.6207 | 0.8866 |
| Peroxisomes | 0.0052 | 0.013 | 0 | 0 | 0.0015 | 0 | 0.0054 | 0 | 0.005 | 0.001 | 0.0003 | 0.0002 | 0.0122 | 0 | 0.0024 | 0.0173 | 0.0005 | 0.001 |
| Punctate Nuclear | 0.0178 | 0.0008 | 0.0012 | 0.0012 | 0.0131 | 0.0004 | 0.0142 | 0.0006 | 0.0033 | 0.0022 | 0.0064 | 0.0027 | 0.0093 | 0.0002 | 0.0014 | 0.0154 | 0.0345 | 0.0005 |
| Vacuole | 0.0009 | 0.0002 | 0.0001 | 0.0005 | 0.001 | 0.0004 | 0.0021 | 0 | 0.0033 | 0.0011 | 0.0057 | 0.001 | 0.0066 | 0.0002 | 0.0011 | 0.0058 | 0.0148 | 0.0004 |
| Vacuole Periphery | 0.0024 | 0.001 | 0.0009 | 0.0065 | 0.0072 | 0.0021 | 0.0019 | 0.0001 | 0.0019 | 0.0073 | 0.0128 | 0.0026 | 0.0019 | 0.0013 | 0.0016 | 0.0067 | 0.0184 | 0.0025 |
Sequencing Data
| R1 | R2 | |||||||||
|---|---|---|---|---|---|---|---|---|---|---|
| G1 Post-START | S/G2 | Metaphase | Anaphase | Telophase | G1 Post-START | S/G2 | Metaphase | Anaphase | Telophase | |
| Gene Expression | 36.7281 | 12.5742 | 8.6394 | 23.4021 | 27.3559 | 36.4474 | 9.8885 | 7.4686 | 15.4283 | 32.3779 |
| Translational Efficiency | 1.6934 | 0.7447 | 1.3134 | 0.8732 | 1.4955 | 1.9626 | 0.9753 | 1.0228 | 0.9366 | 1.2628 |
Hit Data
| Dataset | Hit |
|---|---|
| Protein Concentration | ✔ |
| Protein Localization | ✔ |
| Gene Expression | ✔ |
| Translational Efficiency | ✘ |
Endocytosis
| Temp | Actin Patch (Sac6-tdTomato) | Cortical Patch (Sla1-GFP) | Late Endosome (Snf7-GFP) | Vacuole (Vph1-GFP) |
|---|---|---|---|---|
| 37℃ | ||||
| RT |
Cell Cycle Omics
CYCLoPs (Pol12-GFP)
| Gene / Allele | Actin Patch (Sac6-tdTomato) | Cortical Patch (Sla1-GFP) | Late Endosome (Snf7-GFP) | Vacuole (Sac6-tdTomato) |
|---|
| Gene | Images |
|---|
| Gene | Images |
|---|
Images are not yet available
Images are not yet available